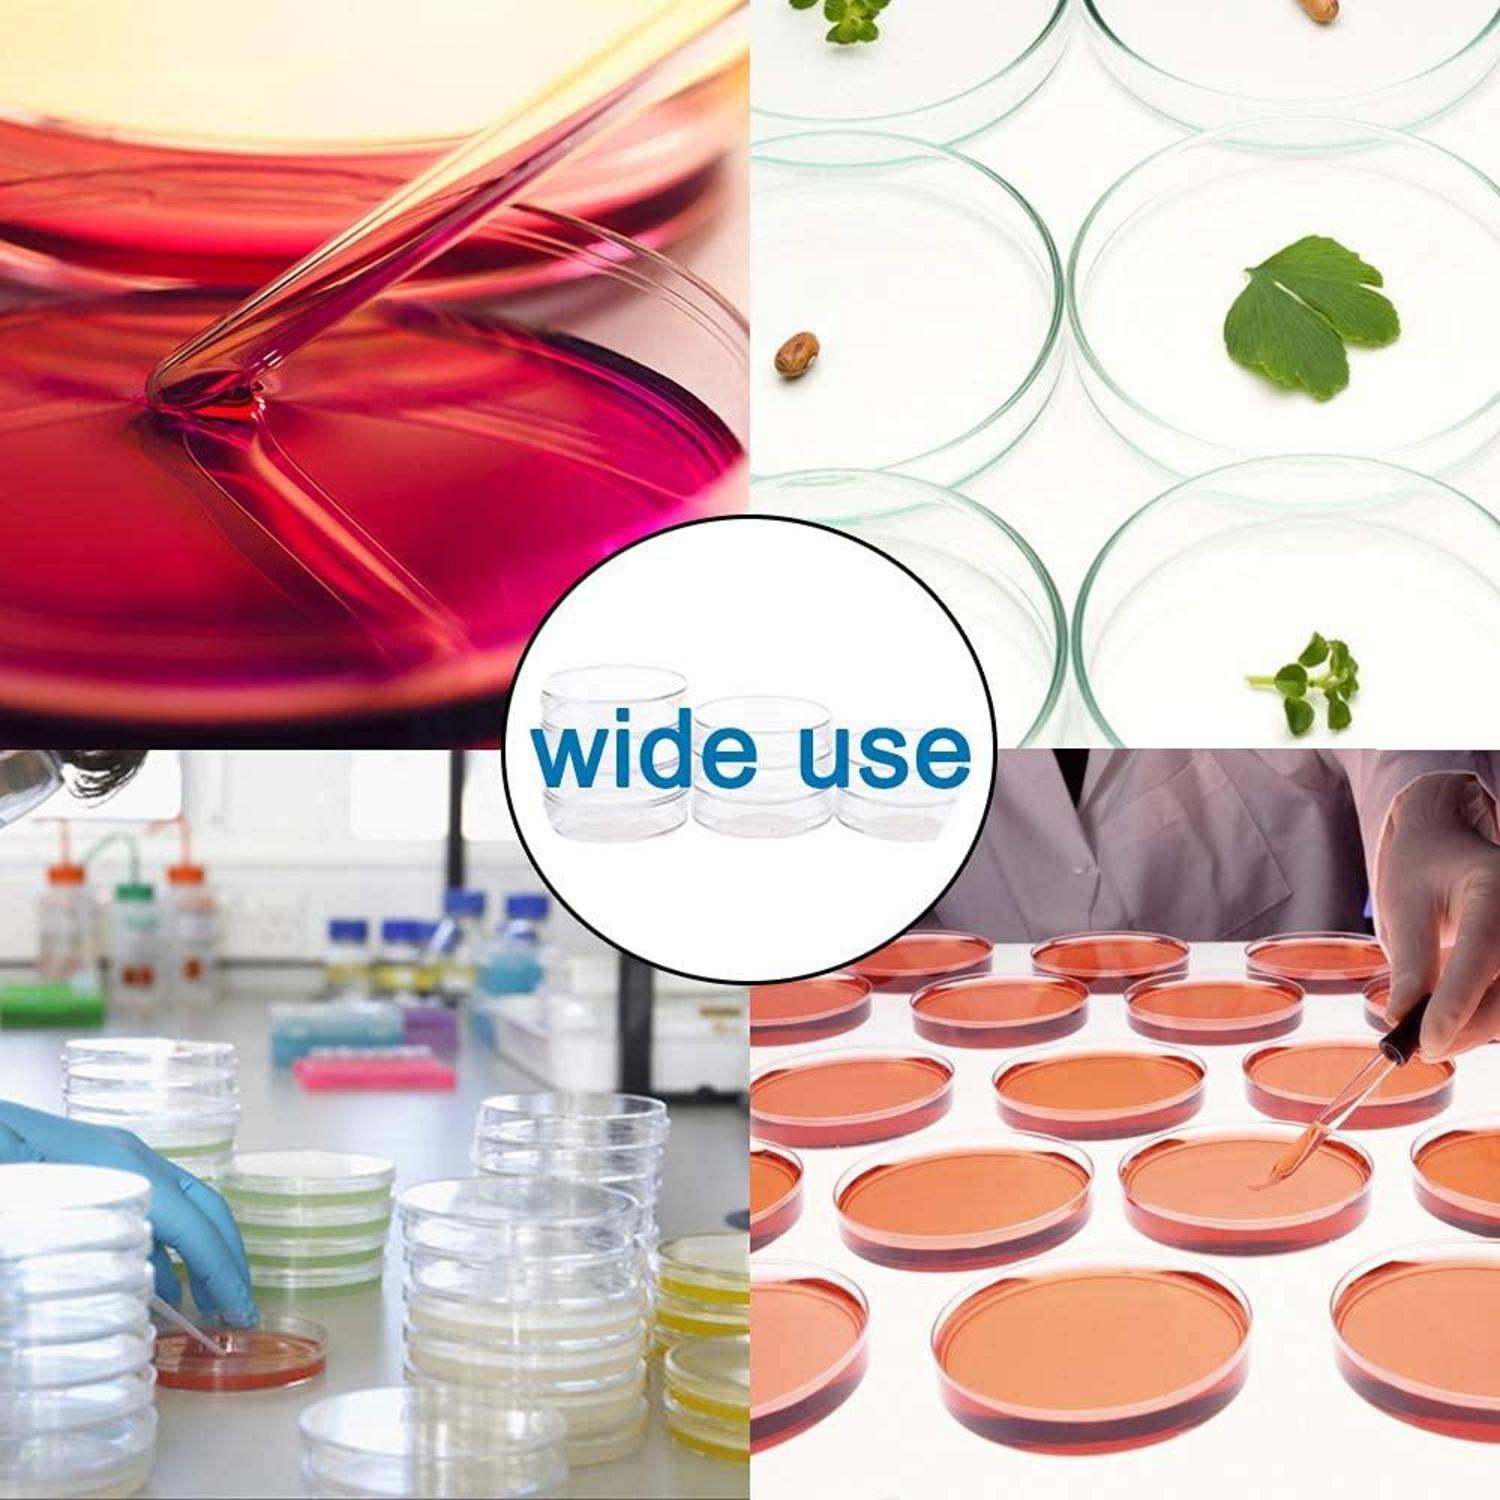
Petrischalen Set mit Deckel 20 Stück steril 70mm x 15mm Labor
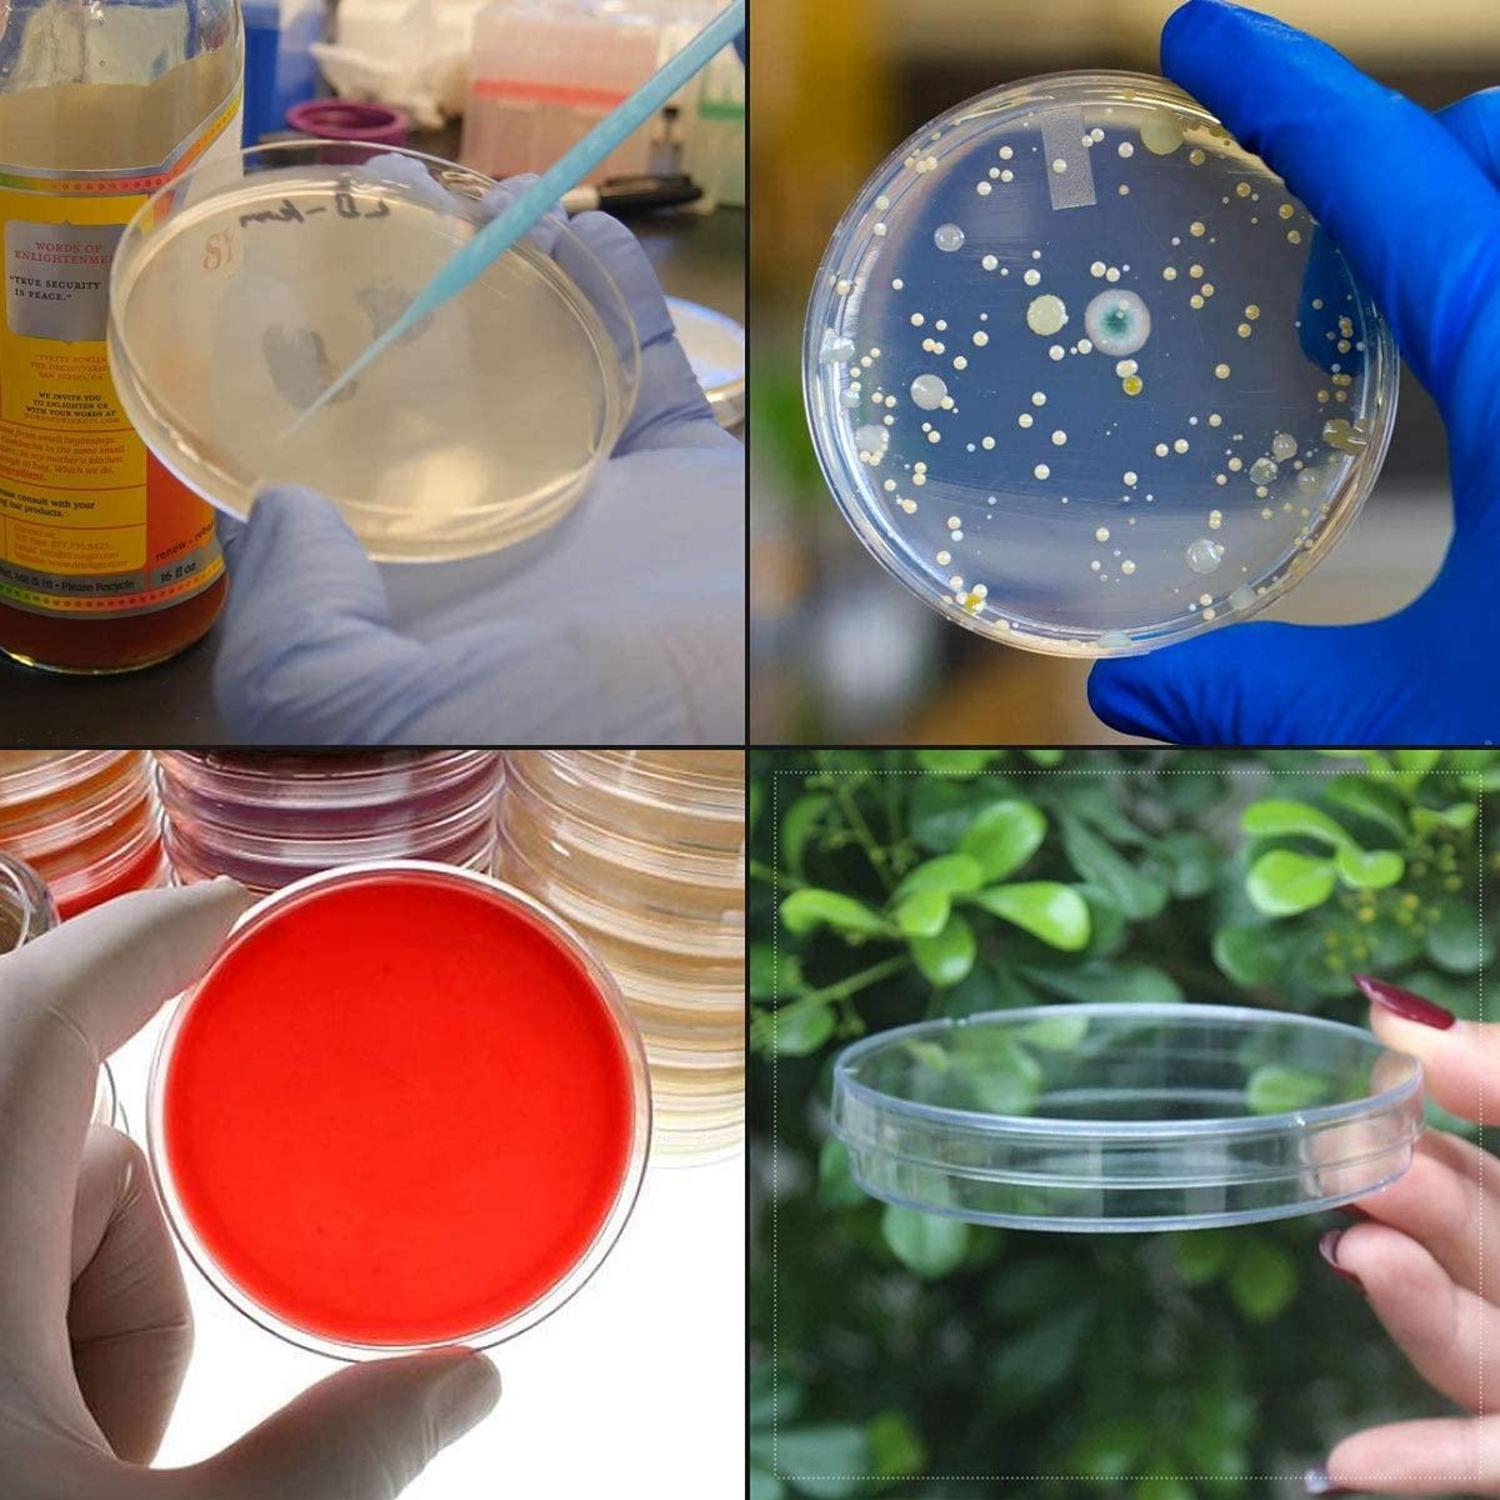
Petrischalen mit Deckel 20 Stück 70x15mm für Bakterienkultur

Häufig gestellte Fragen (FAQ)
Hier finden Sie Antworten auf häufig gestellte Fragen rund um Ihren Einkauf bei Luxus-Kollektion. Wir möchten, dass Sie sorglos und informiert einkaufen können. Sollten Sie dennoch weitere Fragen oder Unsicherheiten haben, kontaktieren Sie uns jederzeit – wir sind gerne für Sie da!